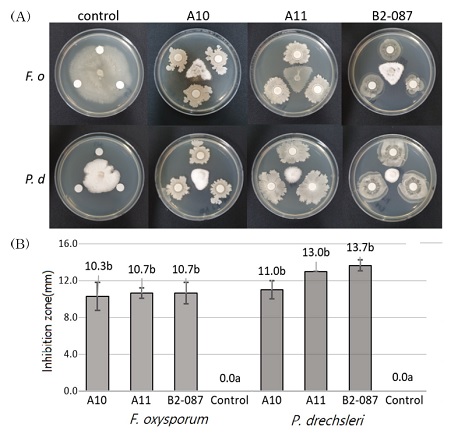
Fig. 1.

Bacillus spp.에 의한 황기의 생육촉진 및 토양병해 방제효과
This is an open access article distributed under the terms of the Creative Commons Attribution Non-Commercial License (http://creativecommons.org/licenses/by-nc/3.0/) which permits unrestricted non-commercial use, distribution, and reproduction in any medium, provided the original work is properly cited.
Abstract
This study investigated potential biological control activities, involving the promotion of growth and antifungal activity against Fusarium oxysporum and Phytophthora drechsleri.
Among the microorganisms isolated from an Astragalus cultivation area and from Korean kimchi, three species were selected. These included A11, which displayed excellent pathogen mycelial suppression ability in dual culture tests. It was identified as Bacillus sp. on the basis of 16s rRNA sequencing. Growth promoting ability was tested by dispensing the three selected strains in pots, to be cultured for 4 weeks. The strain A11 increased the fresh plant weight by 50.8% and increased the fresh root weight by 36.6% compared to untreated samples. The respective increases of the other strain were 18.4% and 35.6% by strain, A10, and 28.0% and 31.1% by strain B2-087. In terms of pathogen control, when the A11, A10, and B2-087 were alternatively tested for 4 weeks against F. oxysporum or P. drechsleri, the A11 control rate was 74.1% compared to the group that received no treatment. Meanwhile, the others had shown control rates between 70.4% and 18.5%.
The three selected strains induced the growth of A. membranaceus Bunge, which suppressed the development of root rot and wilt disease.
Keywords:
Astragalus membranaceus Bunge, Bacillus, Biological Control, Fusarium oxysporum, Phytophthora drechsleri서 언
황기 (Astragalus membranaceus Bunge)는 콩과에 속하는 다년생 초본식물로 우리나라 전국 어느 곳에서나 재배가 가능하며, 특히 추위에 강해 비교적 서늘한 중북부 산간지방인 강원도와 충북, 경기도 일부 지역을 중심으로 주산지가 형성되어 있다. 2019년 기준 황기의 국내 재배면적과 생산량은 각각 193 ㏊와 547 톤으로, 2013년 357 ㏊, 708 톤과 비교하여 지속적인 감소 추세를 보이고 있으며 (MAFRA, 2014; MAFRA, 2020), 최근 농림축산검역본부의 수입량 기준 1,487 톤이 국내 수입되고 있어 (APQA, 2019) 수입량이 지속적으로 증가함을 고려할 때 수요 대비 국내 자급률 확보 노력이 필요한 작물이다.
황기의 주요한 이용 부위는 뿌리로서 예로부터 한방에서는 주피를 벗긴 뿌리를 건조시켜 지산, 이뇨, 강장, 혈압강하 등의 목적으로 이용해 왔다 (Baek et al., 1996). 황기의 약리적 효과는 polysaccharide, saponin, flavonoid 등 성분에 기인하는데, 해당 성분들에 대한 항산화 효과, 간기능 보호 효과, 항바이러스 효과, 항고혈압 효과, 세포성장 효과 및 면역증강 작용 등 다양한 생리활성 작용이 잘 알려져 있다 (Xie, 1994; Rios and Waterman, 1997).
황기는「식품의 기준 및 규격」(제2017-102호, 2017. 12. 15.)에 의해 뿌리와 잎과 싹을 식품으로도 이용 가능한 약용작물이나 대부분 뿌리 생산 위주로 농가에서 재배되고 있다. 황기의 뿌리는 재배 년수가 높을수록 항산화 활성이 높은 것으로 나타나 있으며 (Yin et al., 2009), 주요성분의 함량이 재배년수에 따라 증가하는 경향을 보여 총 astrogaloside, astrogalosideⅣ, flavonoid 등 유효성분의 함량이 1년근, 2년근보다 3년근에서 50% 이상 높으며, polysaccharide 함량 또한 3년근이 2년근에 비해 50% 이상 높아 경제성을 고려한 황기의 최적년근을 3년근으로 보고된 바 (Lim et al., 2014), 일반적으로 재배 년수에 따라 효능과 지표성분의 함량이 변화한다고 알려져 있다.
이와 같은 이유로 황기 뿌리 1년생은 대부분 식품으로 소비되고 약용으로는 3년생 이상의 고년근을 이용하고 있는데, 3년생 이상의 고년근 생산 시 토양전염성 병해에 의한 수량 감소의 우려로 최근 3년근 생산의 주산지인 정선의 황기 재배면적이 ‘13년 89.7 ㏊에서 ’19년 28.9 ㏊로 감소하고 있는 추세이다 (KASS, 2014; KASS, 2020).
황기 수량 감소의 원인이 되는 주요 토양전염병은 시들음병 (Fusarium oxysporum Schltd) (Lee et al., 1991)과 뿌리썩음병 (Phytophthora drechsleri)이 보고되어 있다 (Cho et al., 2000). 시들음병의 경우 1년근에서는 발생 빈도가 미미하지만 재배 년수가 늘어나면 그 빈도가 증가하고 (Ahn et al., 2009), 뿌리썩음병 역시 1년근은 발병지수가 1.3 정도이나 (발병 정도에 따라 0 - 9까지 표기) 3년근의 경우 6.0까지 크게 증가해 (Nam et al., 2006) 농가에서는 주로 1년근을 생산하고있는 실정이며 (Kim et al., 1996) 이러한 이유로 황기 재배농가를 중심으로 황기 토양전염성 병해 경감기술 개발에 대한 현장 요구가 크다.
황기에서 발생하는 뿌리썩음병 (P. drechsleri)과 시들음병 (F. oxysporum)은 생활환의 상당 부분을 토양에서 보내는 토양전염성 병원균으로 여러 작물에 침해하는 넓은 기주 범위를 갖는데, 이들은 토양 내에서 후막포자를 생성하거나 잔여 식물체 조직에서 장기간 생존이 가능해 방제가 어렵고 약용작물과 같이 다년생 작물 재배 및 연작시 병원균이 토양에 누적되어 병 발생이 심해지는 경향을 보인다.
토양전염성병에 대해 다양한 방제가 시도되고 있는 인삼의 경우 뿌리썩음병 (Fusarium solani) 방제를 위해 토양 훈증제를 이용한 토양 소독법을 활용하고 있는데, 해당 방법은 토양 내 유익한 미생물까지 사멸되어 처리 후에는 토양 미생물상을 복원하는 기술이 요구되고 (Bonanomi et al., 2008), 토양훈증제 분해 후 남게 되는 각종 산물이 인삼 생육에 영향을 미칠 수 있다고 하여 (Frick et al., 1998), 화학적 방제에 대한 부작용이 해결되지 않은 실정이다.
이처럼 토양전염성 병해의 특성으로 인한 화학약제의 한계 및 부작용 등을 해결하고자 길항미생물을 이용한 생물학적 방제제가 많은 작물에 대해 도입되어 있는데, 대표적으로 Bacillus subtilis 등이 인삼 점무늬병이나 뿌리썩음병 방제제로서 특허 등록되어있다 (Lee et al., 2009; Jeon et al., 2017).
물론 아직까지 길항미생물을 이용한 미생물 농약 등 생물학적 방제제는 화학농약에 비해 약효 및 약효 지속성이 떨어지고 효과적인 방제를 위해서는 습도와 온도가 적절해야 하는 등의 문제점이 있으나, 생태계에 영향을 주지 않으면서 병해충을 억제하고 농작물의 생장을 촉진하는 (Park, 2011) 등 많은 이점은 여전히 큰 가치를 지닌다.
그럼에도 황기의 경우 현재까지 미생물을 이용한 생물학적 방제가 실용화되어 있지 않아 본 연구를 통해 황기의 토양전염성 병해를 유발하는 원인균에 길항능력을 나타내는 미생물을 선발함으로서 황기의 안정적인 생산과 친환경 재배를 위한 생물학적 방제제로서의 가능성을 검토하였다.
재료 및 방법
1. 병원균 및 유용균주 분리
황기 (Astragalus membranaceus Bunge)의 주요 토양전염성 병해인 시들음병과 뿌리썩음병 원인균에 대해 항균 활성을 나타내는 유용균주를 분리하고자 토양전염병 발생빈도가 높은 8월 집중강우 시기 이후에 강원도 정선과 철원지역의 황기 및 인삼 재배지에서 건전하게 생육 중인 식물체의 근권 토양을 채취하였다.
채취한 시료에서 유용미생물을 분리하기 위해 토양 시료 1g을 멸균수 (sterile water) 9 ㎖에 현탁하고 conical tube에 10−5의 농도로 희석하여 NA 배지 [nutrient agar; beef extract 0.3% (w/v), peptone 0.5% (w/v), agar 1.5% (w/v), Becton, Dickinson and Company, Franklin Lakes, NJ, USA] 에 도말하여 25℃에서 2 일간 배양하였다. 배양 후 육안으로 모양과 색이 서로 다른 미생물의 단일 콜로니를 루프를 이용하여 1 차 분리한 뒤 다시 순수 분리하여 73 종을 준비하였다. 추가로 강원도농업기술원 농식품연구소에서 김치 등 한국 전통식품에서 유래한 고초균 96 종을 분양받았으며, 준비된 모든 균주는 20% glycerol에 현탁하여 deep freezer에서 -70℃에 보관하였다.
황기 토양전염성 병해의 주요 병원균인 뿌리썩음병 원인균과 시들음병 원인균은 농촌진흥청 농업유전자원정보센터로부터 P. drechsleri (KACC 40196)와 F. oxysporum f. sp. gladioli (KACC 40051)를 분양받았으며 해당균이 실제 병원성을 나타내는지 확인하기 위해 포트에서 한 달간 육묘한 황기에 병원균을 5 일간 연속 접종하여 각각의 병징 특성을 나타내는 개체의 병반을 분리해 해당 병원균을 재동정하여 확인한 뒤 사용하였다.
병원성 확인을 위해 접종에 사용한 병원균은 시들음병 원인균 (F. oxysporum)의 경우 PDB 배지 [potato dextrose broth; potato starch 0.4% (w/v), dextrose 2.0% (w/v), Becton, Dickinson and Company, Franklin Lakes, NJ, USA] 에서 30℃, 1 일간 배양하여 멸균수와 1 : 1 희석한 후 멸균한 cheese cloths를 이용하여 포자 현탁액만 회수하여 hemocytometer에서 소형분생포자 밀도가 1.0 × 105 conidia/㎖의 농도가 되도록 멸균수와 희석하여 준비하였다. 뿌리썩음병 원인균 (P. drechsleri)은 10% V8A 배지 [V8 juice agar; V8 juice 10%, agar 1.5%, CaCO3 0.1%]에서 5 일간 배양한 균사 절편 4 개 – 5 개를 멸균수 20 ㎖에 침지한 뒤 빛이 조사되는 24℃ 항온기에서 2 일간 배양하여 유주자낭을 충분히 발생시켰다. 배양액은 접종하기 전 10℃ 에서 30 분간 저온 처리하고 1 시간 상온 처리하여 cheese cloths로 유주자현탁액만 회수한 후 hemocytometer에서 유주자가 1.0 × 105 zoospores/㎖ 농도가 되도록 준비하였다.
2. 병원균억제능력 검정
준비한 유용미생물이 시들음병 원인균 F. oxysporum과 뿌리썩음병 원인균 P. drechsleri에 대해 항균활성을 나타내는지 확인하기 위해 대치배양을 통해 균사생장 억제능력을 검정하였다. 시들음병 원인균은 PDA 배지 [potato dextrose agar; potato starch 0.4% (w/v), dextrose 2.0% (w/v), agar 1.5%(w/v), Difco, Sparks, MD, USA]에 접종하고 뿌리썩음병 원인균은 10% V8A 배지에 접종하여 25℃에서 3 일간 배양하여 준비하였다. 준비된 병원균은 균사 선단부에서 cork borer (직경 5 ㎜)로 분리하여 agar disk로 사용하였고, 유용미생물은 LB broth 배지 [Luria Bertani broth; tryptone 1.0% (w/v), yeast extract 0.5% (w/v), sodium chloride 1.0% (w/v), Difco, Sparks, MD, USA]에 접종하여 25℃에서 1 일간 배양한 배양액을 8 ㎜ paper disk에 100 ㎕ 접종하여 사용하였다.
대치배양은 PDA 배지와 NA 배지를 각각 50%씩 혼합한 배지의 petri-dish (SPL life sciences, Pocheon, Korea) 가운데 병원균 agar disk를 치상하고 3 ㎝ 떨어진 곳에 유용미생물을 접종한 paper disk를 치상하여 25℃에서 7 일간 배양한 후 clear zone을 관찰하였다. 병원균의 균사 생장을 억제하는 유용미생물의 길항능력은 clear zone 길이를 3 반복으로 3 차례 시험하여 측정하였다.
3. Protease 생성 검정
대치배양에서 병원균에 대해 균사생장 억제능력이 높은 유용미생물의 protease 분비를 확인하기 위해 증류수 200 ㎖에 nutrient agar 5 g과 skim milk powder 3%를 혼합한 배지를 autoclave (121℃, 30 min)하여 petri dish에 분주하여 준비하였다. 준비된 배지에 cork borer를 이용하여 직경 5 ㎜의 구멍을 뚫은 후 미리 배양해놓은 미생물 배양액 20 ㎕를 접종하였다. 그리고 25℃에서 5 일간 배양한 뒤 배지의 clear zone 형성을 관찰하여 protease 분비를 확인하였다.
4. Siderophore 활성 검정
선발된 유용균주의 siderophore 활성을 알아보기 위해 chrome azurol sulfonate (CAS; Sigma-Aldrich Co., St. Louis, MO, USA) assay를 간단하게 변형한 방법을 사용하였다 (Han et al., 2015).
먼저 염료용액 60.5 ㎎을 증류수 50.0 ㎖에 녹이고 hexadecyltrimethyl ammonium (HDTMA) 72.9 ㎎은 증류수 50.0 ㎖에 녹인 뒤 광을 차단하여 준비하고, Nutrient Agar 20.7 g을 900.0 ㎖ 증류수에 녹인 다음 두 가지 용액을 혼합하여 autoclave (Jeio Teck, Daejeon, Korea)에 고압 멸균하였다. 고압 멸균된 용액은 50℃로 식힌 뒤 거품이 나지 않도록 천천히 섞어 petri dish에 분주하여 chrome azurol S (CAS) 평판배지를 만들었다. 이 후 위의 방법으로 미리 배양해놓은 미생물 배양액을 접종하여 25℃에서 5 일간 배양하고 균주의 콜로니를 중심으로 CAS 배지의 색이 청색에서 점점 옅어지며 투명해지는 clear zone 형성을 통해 sideorophore 생성 여부를 확인하였다.
5. Cellulase 활성 검정
선발된 유용균주의 cellulase 분해 효소 생성 여부를 확인하기 위해 sodium carboxymethyl cellulose (CMC) agar 배지를 Sazci 등 (1986)에서 사용한 방법을 변형하여 제조하였다.
NA 배지 5 g을 증류수 200 ㎖에 녹인 후 sodium carboxymethyl cellulose (CMC) 1%와 congo red 0.01%을 함께 넣어 섞어준 뒤 autoclave를 통해 고압 멸균하여 준비하였다. cellulase 활성 검정 역시 위 방법처럼 미생물 배양액을 접종하여 25℃에서 5 일간 배양하여 배지의 clear zone 형성을 관찰하였다.
6. 유용균주 배양여액의 무 종자 생장촉진 효과검정
선발된 유용균주가 식물 생장촉진에 관여하는 생장촉진물질을 분비하는지 확인하기 위해 각각의 유용균주를 배양한 배양여액과 무 종자 (관동여름무, 국내채종)를 이용하여 생장촉진실험을 수행하였다.
먼저 필터페이퍼를 2 매씩 넣은 90 ㎜ × 15 ㎜ petri dish에 1% sodium hypo chloric acid가 포함된 멸균수를 5 ㎖씩 넣어 충분히 적신 후 무 종자를 12 개씩 일정한 간격으로 치상한 후 1 일간 실온에 경과시켰다. 배양여액은 각각의 유용균주를 LB Broth에서 1 일간 배양한 뒤 syringe filter (RC 0.45 ㎛, Sartorius Stedim Biotech GmbH, Goettingen, Germany)로 필터링하여 멸균수와 1 : 1로 혼합하여 준비하였다. petri dish에 치상한 무 종자는 24 시간 중 16 시간의 광조건에서 각각의 배양여액을 1 ㎖ 씩 5 일간 분주한 뒤 발아한 개체의 초장과 생체중량을 측정하였다.
7. 포트실험을 통한 황기 생장촉진 효과검정
유용균주 3 종의 식물생장 촉진효과를 확인하기 위해 온실에서 포트실험을 실시하였다. 건조기에서 뒤엎기를 포함하여 105℃, 2 시간 동안 소토법으로 살균한 원예상토를 넣은 4 × 4 연결포트에 황기 (A. membranaceus Bunge) 종자를 파종한 뒤 안정적인 양분 흡수 및 뿌리 활착을 위해 저면관수로 14일간 육묘하여 지상부가 고르게 전개된 개체를 준비하였다.
유용미생물 배양액은 1.0 × 105 colony/㎖ 농도로 멸균수와 1 : 1로 희석하여 식물체 지제부에 10 ㎖씩 5 일 간격으로 4 회 관주처리 하였고 마지막 처리일로부터 5 일이 경과한 후 지상부 및 지하부의 생육정도를 측정하였다.
8. 포트실험을 통한 황기 토양전염병 방제효과 검정
황기의 토양전염성 병원균인 뿌리썩음병 원인균 (P. drechsleri)과 시들음병 원인균 (F. oxysporum)에 대한 유용균주 3 종의 방제효과를 확인하기 위해 위 방법으로 살균처리한 원예상토를 넣은 포트에서 30 일간 육묘한 황기 개체를 대상으로 온실 내에서 포트실험을 실시하였다.
처리방법은 처리구별로 유용균주 배양액 10 ㎖를 실험용 주사기를 이용하여 황기 근권에 먼저 관주한 후 관주일로부터 3 일 경과 후 같은 방법으로 원인균을 관주하는 방법으로 4 주간 교호처리 하였다. 각각의 유용균주는 위 검정에서처럼 멸균수와 1 : 1 희석한 뒤 1.0 × 105 colony/㎖ 농도로 사용하였고 시들음병 원인균 (F. oxysporum)은 PDB (potato dextrose broth) 배지에서 30℃, 1 일간 배양하여 멸균수와 1 : 1 희석 후 hemocytometer를 이용하여 1.0 × 105 conidia/㎖의 농도로 접종하였다.
뿌리썩음병 원인균 (P. drechsleri)은 10% V8A 배지에서 5일간 배양한 균사 절편을 cork borer로 떼어내 멸균수 20 ㎖을 넣은 petri dish에 4 개 - 5 개를 침지하고 빛이 조사되는 24℃ 항온기에서 1 일 - 2 일간 배양하여 유주자낭이 충분히 발생한 배양액으로 접종 전 10℃ 저온에서 30 분간 저온처리 후 실온에서 1 시간 방치하여 hemocytometer에서 1.0 × 105 zoospore/㎖의 농도로 유주자가 다량 유출된 배양액을 사용하였다.
원인균에 의한 발병정도는 황기 지하부에 나타나는 병해의 특징에 따라 구분하였는데 시들음병의 경우 지제부 줄기와 가까운 뿌리를 절단하면 도관부가 갈색으로 변색되고, 뿌리썩음병은 뿌리가 검게 변색되어 썩는 병징을 보인다 (RDA, 2015). 이를 참고하여 시들음병 발병정도는 뿌리를 절단하여 도관부 변색을 확인 후, 그 정도에 따라 0에서 3까지 구분하였고, 뿌리썩음병은 뿌리 표면이 검게 변색되며 썩어가는 병반을 크기에 따라 0에서 3까지 구분하였는데, 0은 0%, 1은 1% - 30%, 2는 31% - 60%, 3은 61% 이상으로 총 3 반복 실시하였고, 방제가는 (무처리구발병정도 - 처리구발병정도) / 무처리구발병정도 × 100으로 계산하였다.
9. 유용균주의 동정
선발된 유용균주를 동정하기 위해 16S rRNA 및 gyrA 유전자 계통 발생 분석에 기반한 분자생물학적 방법과 VITEK2 compact (bioMérieux, Marcy-l'Étoile, France)를 이용한 생화학적 방법을 이용하여 특성 분석을 실시하였다. 16S rDNA 염기서열 분석을 위해 chromosomal DNA 추출은 LB Broth에서 24 시간 동안 배양시킨 배양액 3 ㎖을 Higene™ Genomic DNA Prep Kit (BIOFACT Co., Ltd., Daejeon, Korea)의 방법으로 추출하였다. 16s rRNA 부분 증폭은 universal primer인 27F와 1492R primer를 이용하였다.
Polymerase Chain Reaction (PCR)은 CFX96™ Touch Thermal Cycler (BIO-RAD Inc., Hercules, CA, USA)를 사용하여 95℃에서 30 초간 denaturation 하고 65℃에서 30 초, 72℃에서 30 초 과정을 35 회 반복한 후 72℃에서 7 분간 반응시켰다. PCR 산물은 1 × TAE (Tris-acrtate-EDTA) buffer를 이용하여 1% agarose gel에서 30 분간 전기영동 후 ethidium bromide로 염색하여 UV-transilluminator (DAIHAN Scientific, Wonju, Korea)에서 밴드를 확인하였다. 1,600 bp범위에서 증폭된 밴드를 확인 후 염기서열 분석을 의뢰하였다 (Macrogen Inc., Seoul, Korea).
gyrA 유전자를 이용한 염기서열 분석은 프라이머 gyrA-F (5'-CAGTCAGGAAATGCGTACGTCCTT-3') 및 gyrA-R (5'-CAAGGTAATGCTCCAGGCATTGC-3')을 사용하여 서울대학교 농생명과학공동기기원 NICEM (National Instrumentation Center for Environmental Management, Seoul, Korea)에 의뢰하여 동정하였다.
각각의 염기서열 분석결과는 NCBI (https://www.ncbi.nlm.nih.gov/)에서 BLASTN 프로그램을 이용하여 등록된 염기서열과 비교한 뒤 MEGA X 프로그램 (Molecular Evolutionary Genetics Analysis, Pennsylvania State University, University Park, PA, USA)을 이용하여 계통도를 작성하였다.
유용균주의 생화학적 분석은 VITEK2 compact (Biomerieux, Craponne, France) 시스템을 이용하여 제품 매뉴얼에 따라 LB Broth 배지에서 25℃, 1일간 배양한 선발미생물의 집락을 원심 분리하여 루프로 따낸 뒤 이를 멸균된 생리식염수에서 2.0 McF의 탁도로 맞춰 BCL card에 침지시켰다. 침지한 card는 제품 카세트에 장착한 뒤 판독과정을 거쳤다.
10. 통계분석
유용균주와 병원균의 균사생장 억제능력 검정과 포트시험을 통한 생육촉진 및 방제효과 검정 등 모든 실험은 3 회 반복실시하였고, 각 처리별 평균값 차이에 의한 유의성 검정은 SPSS v.24.0 (IBM Co., Armonk, NY, USA)를 활용하여 Duncan’s Multiple Range Test (DMRT)로 5% 수준에서 통계 분석하였다 (p < 0.05).
결과 및 고찰
1. 유용균주의 선발 및 동정
강원도 정선과 철원지역의 황기 (Astragalus membranaceus Bunge)및 인삼 재배지 근권 토양에서 분리한 유용미생물 73종과 강원도농업기술원 농식품연구소에서 분양 받은 고초균 96 종을 황기 시들음병 (F. oxysporum)과 뿌리썩음병 (P. drechsleri) 원인균과 대치 배양하여 항균활성이 높은 유용균주를 선발하였다.
준비한 유용미생물 169 종을 황기 토양전염성 병원균 2 종(F. oxysporum, P. drechsleri)과 대치 배양한 결과 측정한 clear zone의 길이에 따라 균사억제능력이 가장 높은 유용균주 3 종을 선발하였다.
선발한 유용균주 3 종에서 A10은 F. oxysporum과 P. drechsleri에 대해 각각 10.3 ㎜와 11.0 ㎜의 균사억제능력을 나타내었고, A11은 10.7 ㎜, 13.0 ㎜의 균사억제능력을 나타내었다. 그리고 B2-087은 위 병원균에 대해 각각 10.7 ㎜, 13.7 ㎜의 균사억제능력을 보여 유용균주 3 종 중에서 가장 높은 항균활성을 나타냈으나 유의적인 수준은 아니었다 (Fig. 1).
Mycelial growth inhibition tests using the selected useful strains against F. oxysporum and P. drechsleri.(A); F. oxysporum (F. o) was cultured on PDA and P. drechsleri (P. o) was cultured on V8A medium at 25℃ for 3 days, then mycelium disk were placed on the center of PDA + NA medium plate. The selected useful strains were innoculated on 8 ㎜ paper disk and three triangles were placed around the center of the plate. Results are shown for control and each selected useful strain. (B); The lenth of the clear zone was measured after 7 days of dual culture against F. oxysporum and P. drechsleri on PDA + NA medium at 25℃. Error bar is standard deviations of three replicates. And the different alphabets are shown significant differences according to Duncan’s Multiple Range Test (DMRT, p < 0.05).
항균활성이 가장 높은 3 종의 유용균주는 16S rRNA와 gyrA 유전자를 이용한 염기서열 분석과 VITEK2 system을 이용한 생화학적 분석을 통해 동정되었다. 동정 결과 A10은 Bacillus velezensis, B2-087은 Bacillus sp., A11은 Bacillus amyloliquefaciens로 분류되었다 (Fig. 2 and Table 1).

Phylogenetic tree based on partial 16s rRNA and gyrA gene sequences of the selected useful strains of the genus Bacillus.The DNA sequence of the NCBI nucleotide database was sorted using the MEGA X program and the bootstrap value is displayed at the branch node. The Genbank accession numbers of the Bacillus species most similar to the selected useful strains were indicated next to species name.
2. 유용균주의 활성효소 생성 검정
선발한 유용균주 3 종에 대해 clear zone을 형성함으로서 유용미생물의 활성효소 분비 여부를 확인할 수 있는 배지를 제작하여 측정한 결과, protease와 siderophore 활성은 유용균주 3 종 모두 확인되었고, cellulase 활성은 A10과 B2-087에서 확인되었다 (Fig. 3).

Assay of active substances produced in the selected useful strains.Protease secretion was confrimed in the nutrient agar plate mixed with 3% skim milk powder. Siderophore production was confirmed in the chrome azurol S (CAS) agar plate in which CAS and hexadecyltrimethyl ammonium (HDTMA) were mixed. Cellulase secretion was confirmed in a sodium carboxymethyl cellulose (CMC) agar plate in which 1% CMC and 0.01% congo red were mixed. When the active substance is secreted, a clear zone is formed around the selected useful strain.
일반적으로 토양세균은 다양한 활성효소를 분비하여 식물생장에 도움을 주는 핵심적인 역할을 하는데, 예를 들어 토양화합물의 결합을 파괴하는 주요 효소를 생성하여 식물이 필수적인 무기물을 흡수하는데 도움을 주거나 병원균의 세포벽을 분해하는 가수분해효소를 분비하여 병원균의 생육을 저해하는 길항작용 등을 한다고 알려져 있다.
특히 Bacillus spp.가 분비하는 활성효소 중 protease는 토양 내 난용성 단백질을 식물이 흡수할 수 있는 가급태로 분해하는 역할을 하며, siderophore는 토양 내 철이온과 친화성이 높아 복합체를 형성하여 철이온을 필요로 하는 병원성 진균의 포자형성과 발아관 신장을 억제하면서 식물에게는 철이온을 공급하는 역할을 해 식물 생장 촉진에 도움을 준다 (Niranjan et al., 2005). 마찬가지로 Bacillus spp.가 분비하는 효소 중 cellulase는 (Akira et al., 1987) Phytophthora 속 병원균을 억제한다고 알려져 있다 (Richter et al., 2011).
유용균주 3 종의 protease 등 효소활성 결과는 해당 균주들이 각각의 효소 분비를 통해 황기 생장 촉진에 도움을 주고병 발생을 억제한 것이라 판단된다.
3. 유용균주 배양여액의 무 종자 생장촉진효과 검정
식물의 살아있는 뿌리 주변인 근권 (rhizosphere)의 활성은 비근권에 비하여 매우 높은데, 이는 식물 뿌리에서 저분자 유기화합물이 근권으로 분비되어 근권에서 서식하는 근권미생물에게 좋은 서식처를 제공하기 때문이다. 이로 인해 근권의 효과를 나타내는 지표인 R/S (root/soil)율은 10에서 50까지 이르게 되는데, R/S율은 비근권 토양에 비해 근권 토양이 10에서 50 배의 미생물이 서식하고 있다는 것을 의미한다.
이처럼 식물 근권에 왕성하게 서식하며 식물의 근권 활성과 생장을 촉진하는 토양미생물을 식물생장촉진 근권미생물 (plant growth promoting rhizobacteria, PGPR)이라 하고 이들은 질소고정력을 증가시키고 식물생장촉진호르몬을 생성하는 등 다양한 기작을 통해 종자 발아나 식물의 성장을 촉진시킨다고 알려져 있다 (Kim et al., 2007).
선발한 유용균주의 배양여액을 무 종자에 분주하여 유용균주의 PGPR 관련 물질 생성여부를 확인한 결과, 무처리와 비교하여 A11의 배양여액 처리시 생체중이 34.3% 증가하였고 A10과 B2-087의 배양여액 처리시 21.6% - 29.4% 증가하였다 (Fig. 4). 따라서 유용균주 3 종 모두 무 종자의 생장촉진에 영향을 미치는 PGPR 관련 물질을 생성한다고 판단되었다.

Test of the growth promoting effect of the culture filtrate of the selected useful strains under in vitro.(A); The experiment was performed with Gwandong summer radish (Raphanus raphanistrum subsp. sativus) seeds. (B); Test of the growth promoting effect was measured for 7 days at room temperature after seed on petri dish and control is only water. Error bar is standard deviations of three replicates. And the different alphabets are shown significant differences according to Duncan’s Multiple Range Test (DMRT, p < 0.05).
4. 포트실험을 통한 황기 생장촉진효과 검정
유용균주 3 종이 원예용 인공상토에서 생육촉진효과를 나타내는지 검증하고자 황기를 한 달간 육묘한 포트에서 유용균주를 접종하여 식물체의 지상부 및 지하부 생육정도를 무처리구와 비교 측정하여 그 결과값을 비교하였다.
시험 결과, 유용균주 3 종 처리시 무처리와 비교하여 식물체의 초장과 엽수, 근장에서는 유의적인 차이를 확인할 수 없었으나, 생체중과 생근중에서는 A11의 경우 각각 1.18 g과 0.25 g로 무처리구와 비교하여 50.8%와 36.6% 증가하였고 A10과 B2-087도 각각 18.4% - 35.6%와 28.0% - 31.1% 증가하였다 (Fig. 5 and Table 2).

Growth promotion activity on A. membranaceus bunge in the greenhouse by the selected useful strains.Each selected useful strain culture suspension was inoculated 4 times with a syringe at a concentration of 1 × 105 colony/㎖ and 10 ㎖ to the root area of the plant every 5 days. Control was inoculated with water only, and the result was evaluated 5 days after the last inoculation.

Effect of the selected useful strains on different growth parameters on A. membranaceus bunge in greenhouse pot trials.
이러한 결과는 유용균주의 배양여액을 무 종자에 분주하여 생육촉진효과를 확인한 실험 결과와 일치하였는데, 이는 유용균주 3 종이 토양과 유사한 환경에서도 PGPR로서의 효과를 나타낼 수 있음을 추정할 수 있고 실제 재배지에서도 황기의 파종 이후 초기 생장촉진에 도움이 될 것으로 판단되었다.
5. 포트실험을 통한 황기 지하부 토양전염병 방제효과 검정
황기 뿌리썩음병은 발병 시 지상부가 노랗게 변하고 시들거나 조기 낙엽되며 지하부는 연한 흑갈색으로 변하면서 뿌리가 썩는 증상을 보인다 (Cho et al., 2000). 시들음병은 하엽부터 황화되고 점차 상엽으로 진전되는데, 발병 초기에 지하부 부근의 줄기를 잘라보면 도관부가 갈색으로 변색된다 (RDA, 2015).
이러한 병징의 특성에 따라 발병 시 병징이 가장 먼저 나타나는 지하부를 기준으로 병징의 진전 정도를 측정하였는데, 시들음병은 지하부를 절단하여 도관부의 변색 정도를 측정하였고 뿌리썩음병은 뿌리 표면의 병반 크기를 측정하였다.
유용균주 3 종의 처리구별 병징 진전 정도를 측정한 결과 무처리구에서 F. oxysporum의 발병지수는 2.2를 보였고 P. drechleri의 발병지수는 1.8을 보였다. F. oxysporum에 대한 유용균주의 방제가를 보면 A11이 60.6%의 가장 높은 방제가를 보였고 B2-087은 57.6%의 방제가를 나타냈으며, A10은 45.5%로 가장 낮은 방제가를 나타내었다. 그리고 P. drechsleri에 대해서는 A11이 74.1%의 방제가를 보여 F. oxysporum과 마찬가지로 가장 높은 방제효과를 나타내었고 B2-087은 66.7%의 방제가를 나타냈다. (Fig. 6 and Table 3).

In vivo pathogenicity assay of the selected useful strains from A. membranaceus bunge on the soil borne disease caused by F. oxysporum and P. drechsleri.Each selected useful strain (= A10, A11, and B2-087) or control (= only water) was inoculated into the root area of the plant using a syringe at a concentration of 1 × 105 colony/㎖, and after 3 days, each pathogen was inoculated at a concentration of 1 × 105 conidia/㎖ or 1 × 105 zoospore/㎖. The method was repeated 4 times for 4 weeks and evaluated after 7 days.

Control efficiency of the selected useful strains on F. oxysporum and P. drechsleri on A. membranaceus bunge in the pot experiment.
유용균주 3 종 중에서 B2-087은 surfactin, iturin A, fengycin 등 다양한 항균성 대사물질을 생성하고 인삼 점무늬병 (Alternaria panax) 원인균 등 지상부에 발병하는 병을 방제하는데 효과적으로 사용될 수 있음이 보고된 바 있어 (Lee et al., 2018) 본 실험에서도 해당 균주의 다양한 항균성 대사물질 등이 황기 토양전염병 원인균을 효과적으로 억제하였을 것으로 생각된다. 이에 B2-087과 비슷하거나 좀 더 높은 방제효과를 보인 A11도 다양한 항균성 대사물질을 생성하거나 PGPR 관련 물질 분비를 통해 병원균의 효과적인 억제와 식물체의 건전한 생육에 유의적인 영향을 미쳤다고 추정할 수 있는데, 각 균주에 대한 LC-MS 분석 등을 통해 추가적인 규명이 필요하다.
본 연구에서 사용한 유용균주는 다양한 작물에 대해 생물학적 방제제로 가장 폭넓게 활용되고 있는 Bacillus 속으로 B2-087의 경우 인삼 점무늬병 방제를 위한 미생물제제로 실용화 되어있을 뿐 아니라 황기 토양전염성 병해 원인균에 대해서도 우수한 방제효과를 나타내 다양한 작물에 대해 생물학적 방제제로서의 활용 가능성을 보여주었다.
또한 B2-087보다 근소하게 우수한 방제효과를 보인 A11 역시 방제제로서 이용가능성이 충분하다고 판단된다. 본 연구로 선발한 유용균주의 항균활성 물질탐색 및 생육 최적 조건을 추가적으로 검토하여 실용화를 위한 연구가 동반된다면 고품질 황기 생산을 위한 친환경 방제제로서 충분한 가능성이 있을 것으로 판단된다.
Acknowledgments
본 연구는 농촌진흥청 지역특화작물기술개발사업(과제번호: PJ013625)의 지원에 의해 이루어진 결과로 이에 감사드립니다.
References
- Ahn TJ, Ahn YS, Kim YG and Park CG. (2009). Studies on methods of control Astragalus wilt disease. National Institute of Horticultural and Herbal Science. Rural Development Administration. Wanju, Korea. p.376-377.
- Animal and Plant Quarantine Agency(APQA). (2019). 2018 Year book of plant quarantine statistics. Department of Plant Quarantine. Animal and Plant Quarantine Agency. Gimcheon, Korea. p.215. http://kosis.kr/statHtml/statHtml.do?orgId=114&tblId=DT_114_2012_S0095&conn_path=I2, (cited by 2020 Sep 15).
- Baek NI, Kim YS, Kyung JS and Park KH. (1996). Isolation of anti-hepatotoxic agent from the root of Astragalus membranaceus. The Korean Journal of Pharmacognosy. 27:111-116.
-
Bonanomi G, Chiurazzi M, Caporaso S, Sorbi GD, Moschetti G and Felice S. (2008). Soil solarization with biodegradable materials and its impact on soil microbial communities. Soil Biology and Biochemistry. 40:1989-1998.
[https://doi.org/10.1016/j.soilbio.2008.02.009]

- Cho IC, Ryu KY, Hahm YI, Kim JS and Jee HJ. (2000). Root rot of Astragal(Astragalus membranaceus) caused by Phytophthora drechsleri. Plant Disease Research. 6:88-91.
-
Frick A, Zebarth BJ and Szeto SY. (1998). Behavior of the soil fumigant methyl isothiocyanate in repacked soil columns. Journal of Environmental Quality. 27:1158-1169.
[https://doi.org/10.2134/jeq1998.00472425002700050022x]

-
Han JH, Park GC, Kim JO and Kim KS. (2015). Biological control of Fusarium stalk rot of maize using Bacillus spp. Research in Plant Disease. 21:280-289.
[https://doi.org/10.5423/RPD.2015.21.4.280]

- Jeon YH, Kim YS, Kim KH, Lee SW and Park GH. (2017). Bacillus subtilis strain YGB70 and microbial agent for prevention of ginseng root rot pathogens comprising the same. Korea. Patent. 101905045.
- Kim GH, Kim GY, Kim JK, Sa DM, Seo JS, Son BG, Yang JU, Eom GC, Lee SE, Jeong GY, Jeong DY, Jeong YT, Jeong JB, and Hyeon HN. (2007). Soil science. Hyangmunsa. Seoul, Korea. p.255.
- Kim YG, Chang YH, Lee ST and Yu HS. (1996). Studies on planting density and labor-saving in machine sowing for Astragalus membranaceus Bunge. Korean Journal of Medicinal Crop Science. 4:157-162.
- Korea Agricultural statistics Service(KASS). (2014). 2013 Year Special crop production statistics. Korea Agricultural Statistics Service. Sejong, Korea. https://kass.mafra.go.kr/kass/common/ClipReport.jsp?levCd1=6420000&levCd2=&levCd3=&survId=96&filePath=md%2Freport&fileName=RP9600001&search_Upr_Cd=6420000&search_Org_Cd=&search_Sub_Org_Cd=&search_Upr_Nm=%EA%B0%95%EC%9B%90%EB%8F%84&search_Org_Nm=%EC%A0%84%EC%B2%B4&search_Sub_Org_Nm=&search_Org_Full_Nm=%EA%B0%95%EC%9B%90%EB%8F%84+%EC%A0%84%EC%B2%B4+&search_Ar_Nm=%E3%8E%A1&search_Amt_Nm=&search_Product_Nm=kg&search_Ar_Cd=1&search_Amt_Cd=&search_Weigh_Cd=&search_Research_Year=2013&search_Buryu_Cd=&search_Buryu_, (cited by 2020 Sep 10).
- Korea Agricultural statistics Service(KASS). (2020). 2019 Year Special crop production statistics. Korea Agricultural Statistics Service. Sejong, Korea. https://kass.mafra.go.kr/kass/common/ClipReport.jsp?levCd1=6420000&levCd2=&levCd3=&survId=96&filePath=md%2Freport&fileName=RP9600001&search_Upr_Cd=6420000&search_Org_Cd=&search_Sub_Org_Cd=&search_Upr_Nm=%EA%B0%95%EC%9B%90%EB%8F%84&search_Org_Nm=%EC%A0%84%EC%B2%B4&search_Sub_Org_Nm=&search_Org_Full_Nm=%EA%B0%95%EC%9B%90%EB%8F%84+%EC%A0%84%EC%B2%B4+&search_Ar_Nm=%E3%8E%A1&search_Amt_Nm=&search_Product_Nm=kg&search_Ar_Cd=1&search_Amt_Cd=&search_Weigh_Cd=&search_Research_Year=2019&search_Buryu_Cd=&search_Buryu_, (cited by 2020 Sep 10).
- Lee KJ, Jeong JS, Jeong HN, Yoon YJ, Kim SI, Ahn MS, Won JH, Lee SG, Sim JH and Yoon SW. (2018). Development of microbe-based product producing and application method for cultivation of high quality ginseng in stabilized field condition. Gangwondo Agricultural Research and Extension Services. Cheorwon, Korea. p.795-798.
- Lee SG, Yoo SJ and Choi JE. (2009). Composition for protecting ginseng alternaria leaf blight and method for controlling ginseng alternaria leaf blight using the same. Korea. Patent. 101124193.
- Lim JD, Yoo CY, Kim GG and Chung IM. (2014). Development of vaccine adjuvant products and improvement of food materials through KFDA approval in aboveground parts of Astragalus membranaceus. Rural Development Administration. Jeonju, Korea. p.2.
- Ministry of Agriculture, Food and Rural Affairs(MAFRA). (2014). 2013 Special crop production statistics. Ministry of Agriculture, Food and Rural Affairs. Sejong, Korea. p.35.
- Ministry of Agriculture, Food and Rural Affairs(MAFRA). (2020). 2019 Special crop production statistics. Ministry of Agriculture, Food and Rural Affairs. Sejong, Korea. p.58.
-
Nakamura A, Uozumi T and Beppu T. (1987). Nucleotide sequence of a cellulase gene of Bacillus subtilis. European Journal of Biochemistry. 164:317-320.
[https://doi.org/10.1111/j.1432-1033.1987.tb11060.x]

- Nam SY, Kim IJ, Kim MJ, Choi SY, Rho CW, Yun T and Min KB. (2006). Difference of growth and tuber yield by prior crops in Astragalus Membranaceus Bunge. Chungcheongbukdo Agricultural Research and Extension Services. Cheongju, Korea. p.57.
-
Niranjan RS, Shetty HS and Reddy MS. (2005). Plant growth promoting rhizobacteria: Potential green alternative for plant productivity. In Siddiqui ZA. (ed.)., PGPR: Biological and biofertilization. Springer. Dordrecht, Netherlands. p.197-216.
[https://doi.org/10.1007/1-4020-4152-7_7]

- Park KS. (2011). Development of biopesticide and role of Bacillus spp. Korean Industrial Chemistry News. 14:1-11.
-
Richter BS, Ivors K, Shi W and Benson DM. (2011). Cellulase activity as a mechanism for suppression of Phytophthora root rot in mulches. Phytopathology. 101:223-230.
[https://doi.org/10.1094/PHYTO-04-10-0125]

-
Rios JL and Waterman PG. (1997). A review of the pharmacology and toxicology of Astragalus. Phytotheraphy Research. 11:411-418.
[https://doi.org/10.1002/(SICI)1099-1573(199709)11:6<411::AID-PTR132>3.0.CO;2-6]

- Rural Development Administration(RDA). (2015). Standard cultivation guidebook for Astragalus membranaceus Bunge. Rural Development Administration. Jeonju, Korea. p.50-53.
-
Sazci A, Erenler K and Radford A. (1986). Detection of cellulolytic fungi by using congo red as an indicator: A comparative study with the dinitrosalicyclic acid reagent method. Journal of Applied Bacteriology. 61:559-562.
[https://doi.org/10.1111/j.1365-2672.1986.tb01729.x]

- Xie ZF. (1994). Classified dictionary of traditional chinese medicine. New World Press. Beijing, China. p.374.
- Yin Y, Heo SI, Jung MJ and Wang MH. (2009). Antioxidant and antidiabetic effects of various sections of Astragalus membranaceus. The Korean Journal of Pharmacognosy. 40:1-5.
